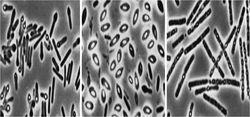
芽胞

定義
芽胞(spore)
芽胞
芽胞芽胞一般只在動物體外才能形成,並受環境影響,當營養缺乏,特別是碳源、氮源或磷酸鹽缺乏時,容易形成芽胞。不同細菌形成芽胞還需不同的條件,如炭疽桿菌須在有氧條件下才能形成芽胞。成熟的芽胞可被許多正常代謝物如丙氨酸、腺苷、葡萄糖、乳酸等激活而發芽,先是芽胞酶活化,皮質層及外殼迅速解聚,水分進入,在合適的營養和溫度條件下,芽胞的核心向外生長成繁殖體,開始發育和分裂繁殖。芽胞並非細菌的繁殖體,而是處於代謝相對靜止的休眠休態,以維持細菌生存的持久體。
芽胞含水量少(約40%),蛋白質受熱不易變性。芽胞具有多層厚而緻密的胞膜,由內向外依次為核心、內膜、芽胞壁、皮質、外膜、芽胞殼和芽胞外衣(圖2-10)。特別是芽胞殼,無通透性,有保護作用,能阻止化學品滲入。芽胞形成時能合成一些特殊的酶,這些酶較之繁殖體中的酶具有更強的耐熱性。芽胞核心和皮質層中含有大量吡啶二羧酸(dipicolinic acid,dpa),占芽胞乾重的5~15%,是芽胞所特有的成分,在細菌繁殖體和其他生物細胞中都沒有。dpa能以一種現尚不明的方式,使芽胞的酶類具有很高的穩定性。芽胞形成過程中很快合成dpa,同時也獲得耐熱性。芽胞呈圓形或橢圓形,其直徑和在菌體內的位置隨菌種而不同,例如,炭疽桿菌的芽胞為卵圓形、比菌體小,位於菌體中央;破傷風桿菌芽胞正圓形、比菌體大,位於頂端,如鼓槌狀。這種形態特點有助於細菌鑑別(圖2-11)。芽胞在自然界分布廣泛,因此要嚴防芽胞污染傷口、用具、敷料、手術器械等。芽胞的抵抗力強,對熱力、乾燥、輻射、化學消毒劑等理化因素均有強大的抵抗力,用一般的方法不易將其殺死。有的芽胞可耐100℃沸水煮沸數小時。殺滅芽胞最可靠的方法是高壓蒸汽滅菌。當進行消毒滅菌時往往以芽胞是否被殺死作為判斷滅菌效果的指標。
 芽胞結構模式
芽胞結構模式某些細菌在一定的環境條件下,能在菌體內部形成一個圓形或卵圓形小體,是細菌的休眠方式,稱為內芽胞(endospore),簡稱芽胞(spore)。產生芽胞的細菌都是革蘭陽性菌。
繁殖體
與芽胞相比,未形成芽胞而具有繁殖能力的菌體稱為繁殖體。
形成與發芽
芽胞形成條件:一般只在動物體外才能形成,其形成條件因菌種而異。有的要在需氧條件下形成(如炭疽芽胞桿菌),有的則相反(如破傷風桿菌);多數芽胞形成是在營養缺乏時,但也有例外(如蘇雲金桿菌)。
生物學特性
折光性強,不易著色。大小、形狀、位置因菌種而異,有重要的鑑別價值。(圖1-3)
結構
成熟的芽胞由多層膜結構組成,帶有完整的核質、酶系統和合成菌體組分的結構,保存有細菌的全部生命必須物質。
發芽
在芽胞形成後,可由於某些因素的刺激作用(如機械力、熱等),破壞其芽胞殼,並供給水分和營養,芽胞即可發芽,形成新的菌體。在細菌形成芽胞再發芽的過程中,細菌數量並未增加,故芽胞不是細菌的繁殖方式。(圖)
功能
增加了細菌對外界不良環境的抵抗力。芽胞賦予細菌對多種理化因素(如熱力、乾燥、輻射、化學消毒劑等)強大的抵抗力,使細菌在惡劣的環境中得以長期保持活性。雖然芽胞不能直接引起疾病,但其強大的抵抗力可使病原菌有機會存活下來並在適當條件下致病。
抵抗力強原因
有三:
1.芽胞含水量少,蛋白質受熱後不易變性;
2.芽胞具有多層緻密的厚膜,理化因素不易透入;
3.芽胞中含有一種特有的化學組分吡啶二羧酸(DPA),DPA與鈣結合生成的鈣鹽能提高芽胞中各種酶的熱穩定性。
判斷滅菌效果的指標:因芽胞的抵抗力遠較繁殖體強,故而當進行消毒滅菌時可將芽胞是否被殺死作為判斷滅菌是否徹底的指標。
套用
①滅菌的指標
②細菌鑑別
由於芽胞的各種特殊構造,在一般程度上,芽胞代表著生物學上滅菌難度的最高點,因此常以滅芽胞的指標作為微生物滅菌的標準。實驗室一般採用高壓蒸汽滅菌,分為兩種方式:120℃,保持20min;115℃,保持20min.。前者作為一般培養基的滅菌方式,後者為含糖培養基的滅菌。
鑑別方式
鑑別芽胞的方式有專門額染色方式:芽胞染色法。
方法是:
製備苗液:1)加1-2滴無菌水於小試管中,用接種環從斜面上挑取2-3環的菌體於試管中並充分打勻,製成濃稠的菌液。2)加染色液:加5%孔雀綠水溶液2-3滴於小試管中,用接種環攪拌使染料與菌液充分混合。 3)加熱:將此試管浸於沸水浴(燒杯),加熱15-20min。 4)塗片:用接種環從試管底部挑數環菌液於潔淨的載玻片上,做成塗面晾乾。 5)固定:將塗片通過酒精燈火焰3次。 6)脫色:用水洗直至流山的水中無孔雀綠顏色為止。 7)復染:加番紅水溶液染色5min後,傾去染色液,不用水洗直接用吸水紙吸乾。8)鏡檢:先低倍,再高倍,最後用油鏡觀察。結果:芽胞呈綠色,芽胞囊和菌體為紅色。
(2)Schaeffer與Fulton氏染色法 1)塗片:按常規方法將待檢細菌製成一薄的塗片。2)晾乾固定:待塗片晾乾後在酒精燈火焰上通過2-3 次3)染色: ①加染色液:加5%孔雀綠水溶液於塗片處(染料以鋪滿塗片為度),然後將塗片放在銅板上,用酒精燈火焰加熱至染液冒蒸汽時開始計算時間,約維持15-20mm。加熱過程中要隨時添加染色液,切勿讓標本乾涸(加熱時溫度不能太高)。 ②水洗:待破片冷卻後,用水輕輕地沖洗,直至流出的水中無染色液為止。 ③復染:用番紅液染色5m。 ④水洗、晾乾或吸乾。 ⑤鏡檢:先低倍,再高倍,最後在油鏡下觀察。 結果:芽胞呈綠色,菌體為紅色。
相關介紹
芽胞含水量少(約40%),蛋白質受熱不易變性。芽胞具有多層厚而緻密的胞膜,由內向外依次為核心、內膜、芽胞壁、皮質、外膜、芽胞殼和芽胞外衣。
特別是芽胞殼,無通透性,有保護作用,能阻止化學品滲入。芽胞形成時能合成一些特殊的酶,這些酶較之繁殖體中的酶具有更強的耐熱性。芽胞核心和皮質層中含有大量吡啶二羧酸(dipicolinicacid,dpa),占芽胞乾重的5~15%,是芽胞所特有的成分,在細菌繁殖體和其他生物細胞中都沒有。
dpa能以一種現尚不明的方式,使芽胞的酶類具有很高的穩定性。芽胞形成過程中很快合成dpa,同時也獲得耐熱性。芽胞呈圓形或橢圓形,其直徑和在菌體內的位置隨菌種而不同,例如,炭疽桿菌的芽胞為卵圓形、比菌體小,位於菌體中央;破傷風桿菌芽胞正圓形、比菌體大,位於頂端,如鼓槌狀。這種形態特點有助於細菌鑑別(圖2-11)。芽胞在自然界分布廣泛,因此要嚴防芽胞污染傷口、用具、敷料、手術器械等。
芽胞的抵抗力強,對熱力、乾燥、輻射、化學消毒劑等理化因素均有強大的抵抗力,用一般的方法不易將其殺死。有的芽胞可耐100℃沸水煮沸數小時。殺滅芽胞最可靠的方法是高壓蒸汽滅菌。當進行消毒滅菌時往往以芽胞是否被殺死作為判斷滅菌效果的指標。

